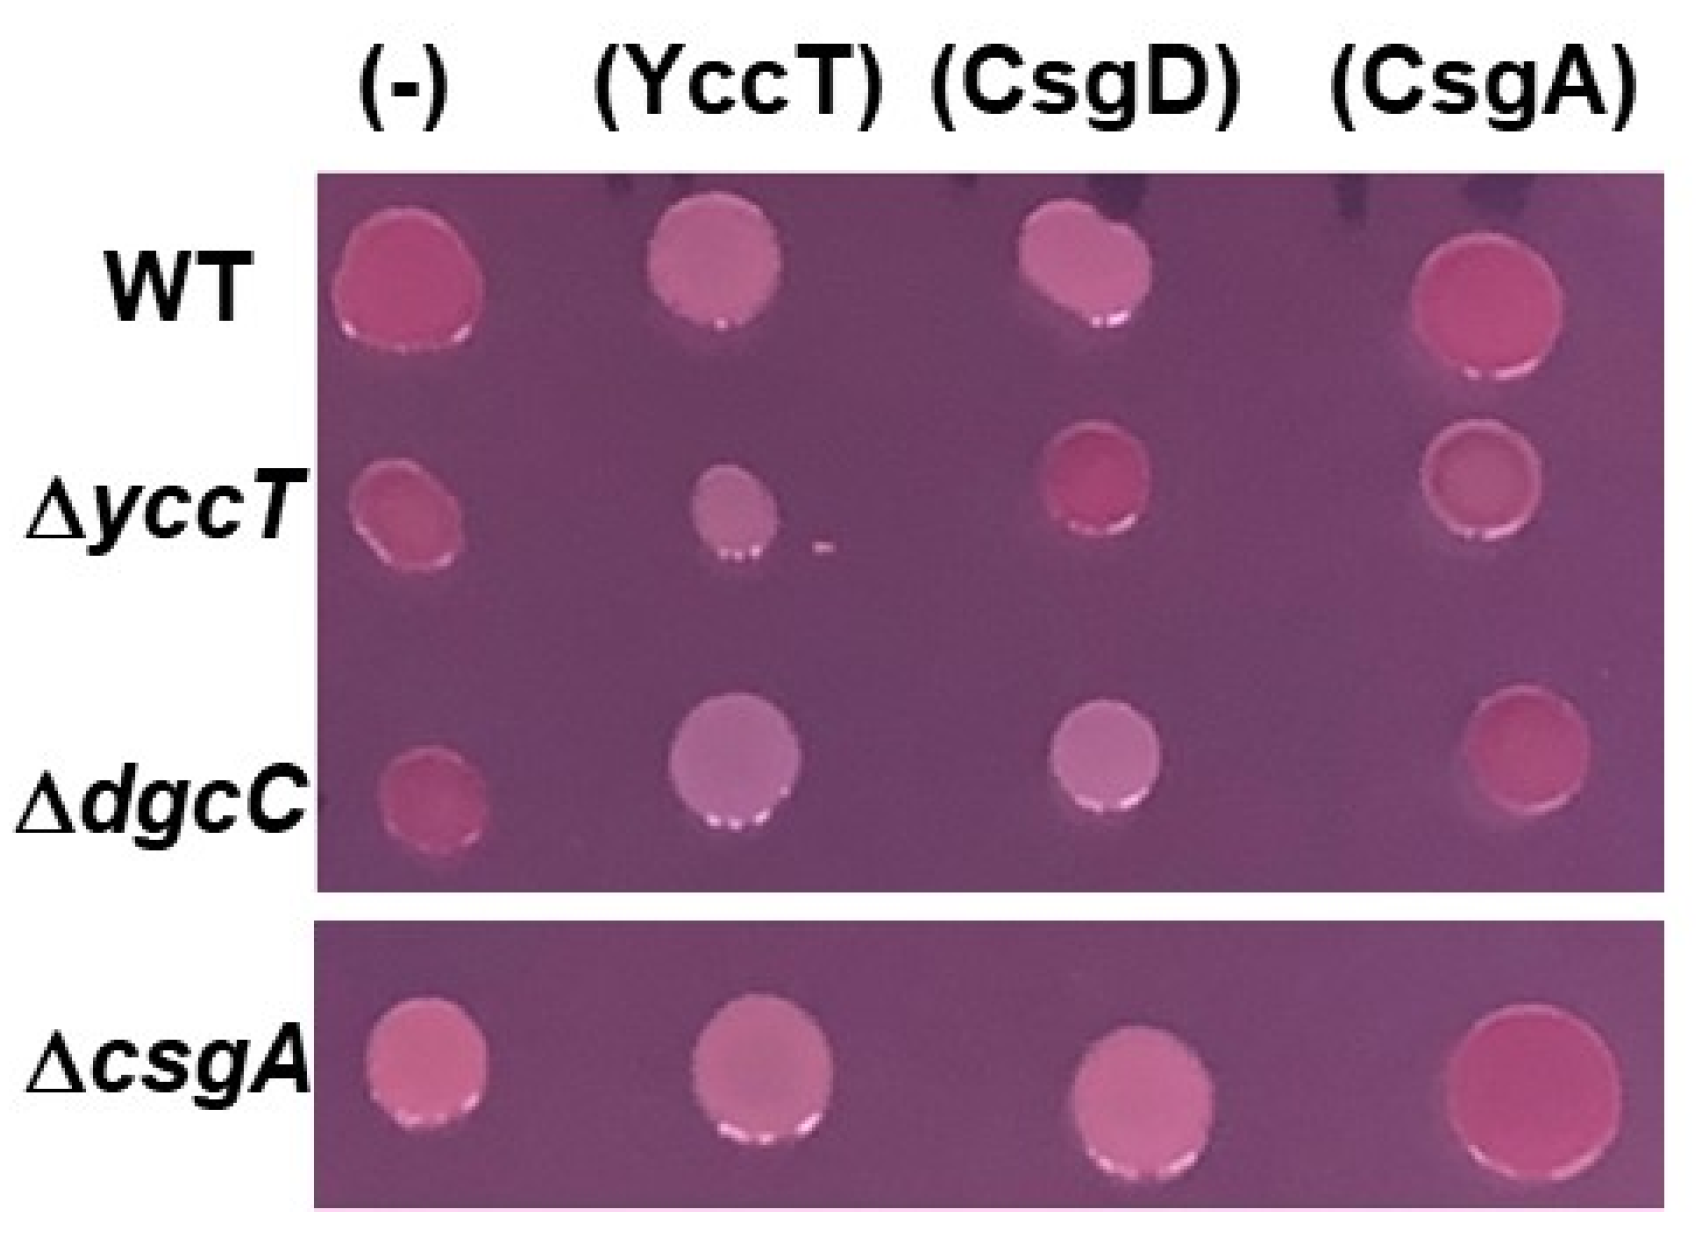
Ijms 24 04357 g002 Ijms 24 04357 g002

CsgI (YccT) Is a Novel Inhibitor of Curli Fimbriae Formation in Escherichia coli Preventing CsgA Polymerization and Curli Gene Expression
Abstract
1. Introduction
2. Results
2.1. Inhibition of Curli Formation by CsgD Overexpression and Identification of the Responsible Gene
2.2. Effect of YccT Overexpression on Curli Fimbriae Formation
2.3. Effects of CsgD Overexpression on csgA and yccT Expression
2.4. Effect of YccT on CsgA Amyloid Fiber Formation In Vitro
2.5. Effect of YccT Overexpression on CsgA Expression
2.6. Effects of Deletion of Signal Peptide Sequence of YccT on Curli Formation and YccT Localization
2.7. Involvement of the Main Stress Response Systems in the Regulation of csgD and csgBA Expression by YccT
2.8. Effect of EnvZ/OmpR on YccT Localization
3. Discussion
4. Materials and Methods
4.1. Bacterial Strains and Culture Conditions
4.2. Plasmid Construction
4.3. Northern Blot Analysis
4.4. Expression and Purification of YccT and CsgA
4.5. Periplasmic Extract Preparation
4.6. In Vitro ThT Amyloid Polymerization Assay
- Fi = Fluorescence intensity of each sample
- Fmax = the highest fluorescence intensity in samples with CsgA
- F0 = background fluorescence intensity obtained for samples containing only Kpi buffer and ThT
4.7. Determination of YccT Localization Using sfGFP
4.8. Reporter Assay of the csgD Promoter
4.9. Western Blot
4.10. Detection of OmpR Phosphorylation by Phos-Tag SDS–PAGE
4.11. Congo Red Plate Assay to Detect the Curli Fimbriae Formation
Supplementary Materials
Author Contributions
Funding
Institutional Review Board Statement
Informed Consent Statement
Data Availability Statement
Acknowledgments
Conflicts of Interest
References
- Karatan, E.; Watnick, P. Signals, regulatory networks, and materials that build and break bacterial biofilms. Microbiol. Mol. Biol. Rev. 2009, 73, 310–347. [Google Scholar] [CrossRef] [PubMed]
- Branda, S.S.; Vik, S.; Friedman, L.; Kolter, R. Biofilms: The matrix revisited. Trends Microbiol. 2005, 13, 20–26. [Google Scholar] [CrossRef] [PubMed]
- Flemming, H.C.; Wingender, J. The biofilm matrix. Nat. Rev. Microbiol. 2010, 8, 623–633. [Google Scholar] [CrossRef] [PubMed]
- Davey, M.E.; O’Toole, G.A. Microbial biofilms: From ecology to molecular genetics. Microbiol. Mol. Biol. Rev. 2000, 64, 847–867. [Google Scholar] [CrossRef]
- Chapman, M.R.; Robinson, L.S.; Pinkner, J.S.; Roth, R.; Heuser, J.; Hammar, M.; Normark, S.; Hultgren, S.J. Role of Escherichia coli curli operons in directing amyloid fiber formation. Science 2002, 295, 195–205. [Google Scholar] [CrossRef]
- Hung, C.; Zhou, Y.; Pinkner, J.S.; Dodson, K.W.; Crowley, J.R.; Heuser, J.; Chapman, M.R.; Hadjifrangiskou, M.; Henderson, J.P.; Hultgren, S.J. Escherichia coli biofilms have an organized and complex extracellular matrix structure. mBio 2013, 4, e00645-13. [Google Scholar] [CrossRef]
- Barak, J.D.; Gorski, L.; Naraghi-Arani, P.; Charkowski, A.O. Salmonella enterica virulence genes are required for bacterial attachment to plant tissue. Appl. Environ. Microbiol. 2005, 71, 5685–5691. [Google Scholar] [CrossRef]
- Cookson, A.L.; Cooley, W.A.; Woodward, M.J.; Dinh, T.; Bernhardt, T.G. The role of type 1 and curli fimbriae of Shiga toxin-producing Escherichia coli in adherence to abiotic surfaces. Int. J. Med. Microbiol. 2002, 292, 195–205. [Google Scholar] [CrossRef]
- Pratt, L.A.; Kolter, R. Genetic analysis of bacterial biofilm formation. Curr. Opin. Microbiol. 1999, 2, 598–603. [Google Scholar] [CrossRef]
- Vidal, O.; Longin, R.; Prigent-Combaret, C.; Dorel, C.; Hooreman, M.; Lejeune, P. Isolation of an Escherichia coli K-12 mutant strain able to form biofilms on inert surfaces: Involvement of a new ompR allele that increases curli expression. J. Bacteriol. 1998, 180, 2442–2449. [Google Scholar] [CrossRef]
- Mika, F.; Hengge, R. Small RNAs in the control of RpoS, CsgD, and biofilm architecture of Escherichia coli. RNA Biol. 2014, 11, 494–507. [Google Scholar] [CrossRef]
- Hammar, M.; Arnqvist, A.; Bian, Z.; Olsén, A.; Normark, S. Expression of two csg operons is required for production of fibronectin- and Congo red-binding curli polymers in Escherichia coli K-12. Mol. Microbiol. 1995, 18, 661–670. [Google Scholar] [CrossRef]
- Nenninger, A.A.; Robinson, L.S.; Hultgren, S.J. Localized and efficient curli nucleation requires the chaperone-like amyloid assembly protein CsgF. Proc. Natl. Acad. Sci. USA 2009, 106, 900–905. [Google Scholar] [CrossRef]
- Nenninger, A.A.; Robinson, L.S.; Hammer, N.D.; Epstein, E.A.; Badtke, M.P.; Hultgren, S.J.; Chapman, M.R. CsgE is a curli secretion specificity factor that prevents amyloid fibre aggregation. Mol. Microbiol. 2011, 81, 486–499. [Google Scholar] [CrossRef]
- Robinson, L.S.; Ashman, E.M.; Hultgren, S.J.; Chapman, M.R. Secretion of curli fibre subunits is mediated by the outer membrane-localized CsgG protein. Mol. Microbiol. 2006, 59, 870–881. [Google Scholar] [CrossRef]
- Evans, M.L.; Chorell, E.; Taylor, J.D.; Åden, J.; Götheson, A.; Li, F.; Koch, M.; Sefer, L.; Matthews, S.J.; Wittung-Stafshede, P.; et al. The bacterial curli system prossesses a potent and selective inhibitor of amyloid formation. Mol. Cell 2015, 57, 445–455. [Google Scholar] [CrossRef]
- Kayed, R.; Head, E.; Thompson, J.L.; McIntire, T.M.; Milton, S.C.; Cotman, C.W.; Glabe, C.G. Common structure of soluble amyloid oligomers implies common mechanism of pathogenesis. Science 2003, 300, 486–489. [Google Scholar] [CrossRef]
- Kayed, R.; Sokolov, Y.; Edmonds, B.; McIntire, T.M.; Milton, S.C.; Hall, J.E.; Glabe, C.G. Permeabilization of lipid bilayers is a common conformation-dependent activity of soluble amyloid oligomers in protein misfolding diseases. J. Biol. Chem. 2004, 279, 46363–46366. [Google Scholar] [CrossRef]
- Evans, M.L.; Schmidt, J.C.; Ilbert, M.; Doyle, S.M.; Quan, S.; Bardwell, J.C.; Jakob, U.; Wickner, S.; Chapman, M.R. E. coli chaperones DnaK, Hsp33 and Spy inhibit bacterial functional amyloid assembly. Prion 2011, 5, 323–334. [Google Scholar] [CrossRef]
- Taylor, J.D.; Hawthorne, W.J.; Lo, J.; Dear, A.; Jain, N.; Meisl, G.; Andreasen, M.; Fletcher, C.; Koch, M.; Darvill, N.; et al. Electrostatically-guided inhibition of curli amyloid nucleation by the CsgC-like family of chaperones. Sci. Rep. 2016, 6, 24656. [Google Scholar] [CrossRef]
- Gerstel, U.; Park, C.; Römling, U. Complex regulation of csgD promoter activity by global regulatory proteins. Mol. Microbiol. 2003, 49, 639–654. [Google Scholar] [CrossRef] [PubMed]
- Jubelin, G.; Vianney, A.; Beloin, C.; Ghigo, J.M.; Lazzaroni, J.C.; Lejeune, P.; Dorel, C. CpxR/OmpR interplay regulates curli gene expression in response to osmolarity in Escherichia coli. J. Bacteriol. 2005, 187, 2038–2049. [Google Scholar] [CrossRef] [PubMed]
- Ogasawara, H.; Yamada, K.; Kori, A.; Yamamoto, K.; Ishihama, A. Regulation of the Escherichia coli csgD promoter: Interplay between five transcription factors. Microbiology 2010, 156, 2470–2483. [Google Scholar] [CrossRef] [PubMed]
- Brown, P.K.; Dozois, C.M.; Nickerson, C.A.; Zuppardo, A.; Terlonge, J.; Curtiss, R. MlrA, a novel regulator of curli (AgF) and extracellular matrix synthesis by Escherichia coli and Salmonella enterica serovar Typhimurium. Mol. Microbiol. 2001, 41, 349–363. [Google Scholar] [CrossRef]
- Dorel, C.; Vidal, O.; Prigent-Combaret, C.; Vallet, I.; Lejeune, P. Involvement of the Cpx signal transduction pathway of E. coli in biofilm formation. FEMS Microbiol. Lett. 1999, 178, 169–175. [Google Scholar] [CrossRef]
- Evans, M.L.; Chapman, M.R. Curli biogenesis: Order out of disorder. Biochim. Biophys. Acta 2014, 1843, 1551–1558. [Google Scholar] [CrossRef]
- Hufnagel, D.A.; Evans, M.L.; Greene, S.E.; Pinkner, J.S.; Hultgren, S.J.; Chapman, M.R. The catabolite repressor protein-cyclic AMP complex regulates csgD and biofilm formation in uropathogenic Escherichia coli. J. Bacteriol. 2016, 198, 3329–3334. [Google Scholar] [CrossRef]
- Ogasawara, H.; Hasegawa, A.; Kanda, E.; Miki, T.; Yamamoto, K.; Ishihama, A. Genomic SELEX search for target promoters under the control of the PhoQP-RstBA signal relay cascade. J. Bacteriol. 2007, 189, 4791–4799. [Google Scholar] [CrossRef]
- Ogasawara, H.; Yamamoto, K.; Ishihama, A. Regulatory role of MlrA in transcription activation of csgD, the master regulator of biofilm formation in Escherichia coli. FEMS Microbiol. Lett. 2010, 312, 160–168. [Google Scholar] [CrossRef]
- Ogasawara, H.; Shinohara, S.; Yamamoto, K.; Ishihama, A. Novel regulation targets of the metal-response BasS-BasR two-component system of Escherichia coli. Microbiology 2012, 158, 1482–1492. [Google Scholar] [CrossRef]
- Ogasawara, H.; Ishizuka, T.; Yamaji, K.; Kato, Y.; Shimada, T.; Ishihama, A. Regulatory role of pyruvate-sensing BtsSR in biofilm formation by Escherichia coli K-12. FEMS Microbiol. Lett. 2019, 366, fnz251. [Google Scholar] [CrossRef]
- Reshamwala, S.M.S.; Noronha, S.B. Biofilm formation in Escherichia coli cra mutants is impaired due to down-regulation of curli biosynthesis. Arch. Microbiol. 2011, 193, 711–722. [Google Scholar] [CrossRef]
- Saldaña, Z.; Xicohtencatl-Cortes, J.; Avelino, F.; Phillips, A.D.; Kaper, J.B.; Puente, J.L.; Girón, J.A. Synergistic role of curli and cellulose in cell adherence and biofilm formation of attaching and effacing Escherichia coli and identification of Fis as a negative regulator of curli. Environ. Microbiol. 2009, 11, 992–1006. [Google Scholar] [CrossRef]
- Shimada, T.; Katayama, Y.; Kawakita, S.; Ogasawara, H.; Nakano, M.; Yamamoto, K.; Ishihama, A. A novel regulator RcdA of the csgD gene encoding the master regulator of biofilm formation in Escherichia coli. Microbiologyopen 2012, 1, 381–394. [Google Scholar] [CrossRef]
- Ogasawara, H.; Ishizuka, T.; Hotta, S.; Aoki, M.; Shimada, T.; Ishihama, A. Novel regulators of the csgD gene encoding the master regulator of biofilm formation in Escherichia coli K-12. Microbiology 2020, 166, 880–890. [Google Scholar] [CrossRef]
- Ogasawara, H.; Yamamoto, K.; Ishihama, A. Role of the biofilm master regulator CsgD in cross-regulation between biofilm formation and flagellar synthesis. J. Bacteriol. 2011, 193, 2587–2597. [Google Scholar] [CrossRef]
- Vidovic, S.; Liu, X.; An, R.; Mendoza, K.M.; Abrahante, J.E.; Johny, A.K.; Reed, K.M. Transcriptional profiling and molecular characterization of the yccT mutant link: A novel STY1099 Protein with the peroxide stress response and cell division of Salmonella enterica serovar enteritidis. Biology 2019, 8, 86. [Google Scholar] [CrossRef]
- Serra, D.O.; Richter, A.M.; Hengge, R. Cellulose as an architectural element in spatially structured Escherichia coli biofilms. J. Bacteriol. 2013, 195, 5540–5554. [Google Scholar] [CrossRef]
- Yang, J.; Wei, Y.; Yeh, C.; Liou, F.; Chen, W.; Lu, D.; Chen, C.; Pei, J.; Lee, C.; Chen, E.; et al. Recombinant expression of Proteorhodopsin and biofilm regulators in Escherichia coli for nanoparticle binding and removal in a wastewater treatment model. bioRxiv 2018. [Google Scholar] [CrossRef]
- Gualdi, L.; Tagliabue, L.; Bertagnoli, S.; Ieranò, T.; de Castro, C.D.; Landini, P. Cellulose modulates biofilm formation by counteracting curli-mediated colonization of solid surfaces in Escherichia coli. Microbiology 2008, 154, 2017–2024. [Google Scholar] [CrossRef]
- Zakikhany, K.; Harrington, C.R.; Nimtz, M.; Hinton, J.C.D.; Römling, U. Unphosphorylated CsgD controls biofilm formation in Salmonella enterica serovar Typhimurium. Mol. Microbiol. 2010, 77, 771–786. [Google Scholar] [CrossRef] [PubMed]
- Ishihama, A. Prokaryotic genome regulation: A revolutionary paradigm. Proc. Jpn. Acad. Ser. B Phys. Biol. Sci. 2012, 88, 485–508. [Google Scholar] [CrossRef] [PubMed]
- Prigent-Combaret, C.; Brombacher, E.; Vidal, O.; Ambert, A.; Lejeune, P.; Landini, P.; Dorel, C. Complex regulatory network controls initial adhesion and biofilm formation in Escherichia coli via regulation of the csgD gene. J. Bacteriol. 2001, 183, 7213–7223. [Google Scholar] [CrossRef] [PubMed]
- Vianney, A.; Jubelin, G.; Renault, S.; Dorel, C.; Lejeune, P.; Lazzaroni, J.C. Escherichia coli tol and rcs genes participate in the complex network affecting curli synthesis. Microbiology 2005, 151, 2487–2497. [Google Scholar] [CrossRef]
- Heyde, M.; Laloi, P.; Portalier, R. Involvement of carbon source and acetyl phosphate in the external-pH-dependent expression of porin genes in Escherichia coli. J. Bacteriol. 2000, 182, 198–202. [Google Scholar] [CrossRef]
- Hunke, S.; Keller, R.; Müller, V.S. Single integration by the Cpx-envelope stress system. FEMS. Microbiol. Lett. 2012, 326, 12–22. [Google Scholar] [CrossRef]
- Zhou, X.; Keller, R.; Volkmer, R.; Krauss, N.; Scheerer, P.; Hunke, S. Structural basis for two-component system inhibition and pilus sensing by the auxiliary CpxP protein. J. Biol. Chem. 2011, 286, 9805–9814. [Google Scholar] [CrossRef]
- Alphen, W.V.; Lugtenberg, B. Influence of osmolarity of the growth medium on the outer membrane protein pattern of Escherichia coli. J. Bacteriol. 1977, 131, 623–630. [Google Scholar] [CrossRef]
- Mizuno, T.; Mizushima, S. Signal transduction and gene regulation through the phosphorylation of two regulatory components: The molecular basis for the osmotic regulation of the porin genes. Mol. Microbiol. 1990, 4, 1077–1082. [Google Scholar] [CrossRef]
- Russo, F.D.; Silhavy, T.J. EnvZ controls the concentration of phosphorylated OmpR to mediate osmoregulation of the porin genes. J. Mol. Biol. 1991, 222, 567–580. [Google Scholar] [CrossRef]
- Heyde, M.; Portalier, R. Regulation of major outer membrane porin proteins of Escherichia coli K12 by pH. Mol. Gen. Genet. 1987, 208, 511–517. [Google Scholar] [CrossRef]
- Liu, X.; Ferenci, T. Regulation of porin-mediated outer membrane permeability by nutrient limitation in Escherichia coli. J. Bacteriol. 1998, 180, 3917–3922. [Google Scholar] [CrossRef]
- Villarejo, M.; Case, C.C. envZ mediates transcriptional control by local anesthetics but is not required for osmoregulation in Escherichia coli. J. Bacteriol. 1984, 159, 883–887. [Google Scholar] [CrossRef]
- Oshima, T.; Aiba, H.; Masuda, Y.; Kanaya, S.; Sugiura, M.; Wanner, B.L.; Mori, H.; Mizuno, T. Transcriptome analysis of all two-component regulatory system mutants of Escherichia coli K-12. Mol. Microbiol. 2002, 46, 281–291. [Google Scholar] [CrossRef]
- Gerken, H.; Charlson, E.S.; Cicirelli, E.M.; Kenney, L.J.; Misra, R. MzrA: A novel modulator of the EnvZ/OmpR two-component regulon. Mol. Microbiol. 2009, 72, 1408–1422. [Google Scholar] [CrossRef]
- Forst, S.; Delgado, J.; Rampersaud, A.; Inouye, M. In vivo phosphorylation of OmpR, the transcription activator of the ompF and ompC genes in Escherichia coli. J. Bacteriol. 1990, 172, 3473–3477. [Google Scholar] [CrossRef]
- Lukat, G.S.; McCleary, W.R.; Stock, A.M.; Stock, J.B. Phosphorylation of bacterial response regulator proteins by low molecular weight phospho-donors. Proc. Natl. Acad. Sci. USA 1992, 89, 718–722. [Google Scholar] [CrossRef]
- McCleary, W.R.; Stock, J.B. Acetyl phosphate and the activation of two-component response regulators. J. Biol. Chem. 1994, 269, 31567–31572. [Google Scholar] [CrossRef]
- Shin, S.; Park, C. Modulation of flagellar expression in Escherichia coli by acetyl phosphate and the osmoregulator OmpR. J. Bacteriol. 1995, 177, 4696–4702. [Google Scholar] [CrossRef]
- Harlocker, S.L.; Bergstrom, L.; Inouye, M. Tandem binding of six OmpR proteins to the ompF upstream regulatory sequence of Escherichia coli. J. Biol. Chem. 1995, 270, 26849–26856. [Google Scholar] [CrossRef]
- Yoshida, T.; Cai, S.J.; Inouye, M. Interaction of EnvZ, a sensory histidine kinase, with phosphorylated OmpR, the cognate response regulator. Mol. Microbiol. 2002, 46, 1283–1294. [Google Scholar] [CrossRef] [PubMed]
- Yoshida, T.; Qin, L.; Egger, L.A.; Inouye, M. Transcription regulation of ompF and ompC by a single transcription factor, OmpR. J. Biol. Chem. 2006, 281, 17114–17123. [Google Scholar] [CrossRef] [PubMed]
- Shimada, T.; Takada, H.; Yamamoto, K.; Ishihama, A. Expanded roles of two-component response regulator OmpR in Escherichia coli: Genomic SELEX search for novel regulation targets. Genes Cells 2015, 20, 915–931. [Google Scholar] [CrossRef] [PubMed]
- Yao, Y.; Fan, L.; Shi, Y.; Odsbu, I.; Morigen. A spatial control for correct timing of gene expression during the Escherichia coli cell cycle. Genes 2016, 8, 1. [Google Scholar] [CrossRef]
- Kitagawa, M.; Ara, T.; Arifuzzaman, M.; Ioka-Nakamichi, T.; Inamoto, E.; Toyonaga, H.; Mori, H. Complete set of ORF clones of Escherichia coli ASKA library (A complete set of E. coli K-12 ORF archive): Unique resources for biological research. DNA Res. 2005, 12, 291–299. [Google Scholar] [CrossRef]
- Batchelor, E.; Goulian, M. Imaging OmpR localization in Escherichia coli. Mol. Microbiol. 2006, 59, 1767–1778. [Google Scholar] [CrossRef]
- Sugimoto, S.; Arita-Morioka, K.I.; Terao, A.; Yamanaka, K.; Ogura, T.; Mizunoe, Y. Multitasking of Hsp70 chaperone in the biogenesis of bacterial functional amyloids. Commun. Biol. 2018, 1, 52. [Google Scholar] [CrossRef]
- Sugimoto, S.; Yamanaka, K.; Niwa, T.; Terasawa, Y.; Kinjo, Y.; Mizunoe, Y.; Ogura, T. Hierarchical model for the role of J-domain proteins in distinct cellular functions. J. Mol. Biol. 2021, 433, 166750. [Google Scholar] [CrossRef]
- Imada, K.; Minamino, T.; Kinoshita, M.; Furukawa, Y.; Namba, K. Structural insight into the regulatory mechanisms of interactions of the flagella type III chaperone FliT with its binding partners. Proc. Natl. Acad. Sci. USA 2010, 107, 8812–8817. [Google Scholar] [CrossRef]
- Uzzau, S.; Figueroa-Bossi, N.; Rubino, S.; Bossi, L. Epitope tagging of chromosomal genes in Salmonella. Proc. Natl. Acad. Sci. USA 2001, 98, 15264–15269. [Google Scholar] [CrossRef]
- Simons, R.W.; Houman, F.; Kleckner, N. Improved single and multicopy lac-based cloning vectors for protein and operon fusions. Gene 1987, 53, 85–96. [Google Scholar] [CrossRef]
- Wood, W.B. Host specificity of DNA produced by Escherichia coli: Bacterial mutations affecting the restriction and modification of DNA. J. Mol. Biol. 1966, 16, 118–133. [Google Scholar] [CrossRef]
- Datsenko, K.A.; Wanner, B.L. One-step inactivation of chromosomal genes in Escherichia coli K-12 using PCR products. Proc. Natl. Acad. Sci. USA 2000, 97, 6640–6645. [Google Scholar] [CrossRef]
- Baba, T.; Ara, T.; Hasegawa, M.; Takai, Y.; Okumura, Y.; Baba, M.; Datsenko, K.A.; Tomita, M.; Wanner, B.L.; Mori, H. Construction of Escherichia coli K-12 in–frame, single-gene knockout mutants: The Keio collection. Mol. Syst. Biol. 2006, 2, 2006-0008. [Google Scholar] [CrossRef]
- Guzman, L.M.; Belin, D.; Carson, M.J.; Beckwith, J. Tight regulation, modulation, and high-level expression by vectors containing the arabinose PBAD promoter. J. Bacteriol. 1995, 177, 4121–4130. [Google Scholar] [CrossRef]
- Yamamoto, K.; Hirao, K.; Oshima, T.; Aiba, H.; Utsumi, R.; Ishihama, A. Functional Characterization in vitro of All two-component Signal transduction Systems from Escherichia coli. J. Biol. Chem. 2005, 280, 1448–1456. [Google Scholar] [CrossRef]
- Zhou, Y.; Smith, D.R.; Hufnagel, D.A.; Chapman, M.R. Experimental manipulation of the microbial functional amyloid called curli. Methods Mol. Biol. 2013, 966, 53–75. [Google Scholar]
- Miller, J.H. Experiments in Molecular Genetics; Cold Spring Harbor Laboratory Press: New York, NY, USA, 1972. [Google Scholar]
- Barnhart, M.M.; Chapman, M.R. Curli biogenesis and functions. Annu. Rev. Microbiol. 2006, 60, 131–147. [Google Scholar] [CrossRef]

| Strain | Genotype | Source or Reference |
|---|---|---|
| DH5α | F−, 80dlacZΔM15, Δ(lacZYA-argF)U169, deoE, recA1, endA1 hsdR17(rK−,mK+), phoA, supE44, λ−, thi-1, gryA96, relA1 | Takara bio, Shiga, Japan |
| BL21(DE3) | F−, lon-11, Δ(ompT-nfrA)885, Δ(galM-ybhJ)884, λDE3 [lacI, lacUV5-T7 gene 1, ind1, sam7, nin5], Δ46, [mal+]K-12(λS), hsdS10 | [72] |
| BW25113 | F−, Δ(araD-araB)567, ΔlacZ4787(::rrnB-3), λ− rph-1, Δ(rhaD-rhaB)568, hsdR514 | [73] |
| BW27559 | BW25113 Δ(cpxR)623 | [54] |
| BW27870 | BW25113 ΔrcsB1320 | [54] |
| JW1023 | BW25113ΔcsgD::Kan | [74] |
| JW0947 | BW25113ΔyccT::Kan | [74] |
| JW0989 | BW25113ΔwrbA::Kan | [74] |
| JW5130 | BW25113ΔyccU::Kan | [74] |
| JW3127 | BW25113ΔyhbU::Kan | [74] |
| JW3635 | BW25113ΔnlpA::Kan | [74] |
| JW3126 | BW25113ΔyhbT::Kan | [74] |
| JW5531 | BW25113ΔdeaD::Kan | [74] |
| JW5136 | BW25113ΔymdF::Kan | [74] |
| JW1922 | BW25113ΔfliF::Kan | [74] |
| JW1921 | BW25113ΔfliE::Kan | [74] |
| JW1026 | BW25113ΔcsgC::Kan | [74] |
| JW3367 | BW25113ΔenvZ::Kan | [74] |
| JW3368 | BW25113ΔompR::Kan | [74] |
| JW5665 | BW25113ΔbcsA::Kan | [74] |
| BWΔenvZ | Km resistance marker of JW3367 eliminated with pCP20 | This study |
| BWyccT-FLAG | BW25113yccT::3×FLAG | This study |
| BWWcsgD-lacZ | BW25113 λcsgD-lacZ | [36] |
| BWWcsgBA-lacZ | BW25113 λcsgBA-lacZ | [36] |
| BWΔcpxRAcsgD-lacZ | BW27559 λcsgD-lacZ | This study |
| BWΔrcsBcsgD-lacZ | BW27870 λcsgD-lacZ | This study |
| BWΔenvZcsgD-lacZ | BWΔenvZ λcsgD-lacZ | This study |
| Plasmid | Genotype | Source or Reference |
| pBAD18 | araC, rrnBT, amp | [75] |
| pBAD24 | araC, rrnBT, amp | [75] |
| pBADcsgD | pBAD18 with fragment containing yccT ORF | This study |
| pBADyccT | pBAD18 with fragment containing yccT ORF | This study |
| pBADyccT* | pBAD18 with fragment containing signal peptide deleted yccT | This study |
| pBADyccT-FLAG | pBAD18 with fragment containing yccT::3×FLAG | This study |
| pSU311 | Vector containing a 1.9-kb fragment carrying the R6K oriV and the βla gene | [70] |
| pSUB11 | pSU311 with fragment containing 3xFLAG sequence | [70] |
| pKD46 | araC, bla, tL3 | [73] |
| pET-21(a) | Ampr, T7 expression plasmid | Novagen |
| pET21yccT-His | C-terminal His6 tagged with fragment containing yccT::His-tag | This study |
| pET21csgA-His | C-terminal His6 tagged with fragment containing csgA::His-tag | This study |
| pTAKN-2-bsfgfp | pTAKN-2 with fragment containing sfgfp ORF | Gifted by Dr. S. Sugimoto |
| pBADsfgfp | pBAD24 with fragment containing sfgfp ORF | This study |
| pBADyccT-sfgfp | pBAD24 with fragment containing yccT ORF and sfgfp ORF | This study |
| pBADyccT*-sfgfp | pBAD24 with fragment containing dspyccT ORF and sfgfp ORF | This study |
| Primer | Sequence(5′–3′) | |
| yccT(fw)3FLAG | AAATACTTTCCTGCAGTGGGCGGAAAAACAACCATCTTCCGACTACAAAGACCATGACGG | |
| yccT(rv)3FLAG | CCGTAGTTAACTTTCCTACAGATTACTGTAAGCACTTATCCATATGAATATCCTCCTTAG | |
| yccT-s-N | ATAATGGACCGCATCAGTTAGTGTT | |
| yccT-t-N | TCAGGAAGATGGTTGTTTTTCCG | |
| csgD-N-F | TTATCGCCTGAGGTTATCGTTTGC | |
| csgD-N-R | TCTTCAGGCTCTATTATTCTTCTGGATAT | |
| csgB-s-N | TTTATGATGTTAACAATACTGGGTGCGC | |
| csgB-t-N | TTAACGTTGTGTCACGCGAATAGCCATTT | |
| yccT-PET-NdeI-F | GGAGCTACATATGAAAACCGGCATCGTGAGCACCT | |
| yccT-PET-NotI-R | GGCACAAGCGGCCGCGGAAGATGGTTGTTTTTCCG | |
| csgA-NdeI-PETF | GGGGTTTCATATGGGTGTTGTTCCTCAGTACGGCG | |
| csgA-NotI-PETR | ACAAATGGCGGCCGCGTACTGATGAGCGGTCGCGT | |
| T7promoterprimer | TAATACGACTCACTATAGGG | |
| T7terminatorprimer | GCTAGTTATTGCTCAGCGG | |
| yccT-EcoRI-F | AGTATGAATTCAGAAAAATTTTGACACATT | |
| yccT-XbaI-R | CAAGATCTAGACCGAAAAAGCCTGCGCACAG | |
| BAD-SQ-F | CTGTTTCTCCATACCCGTT | |
| BAD-SQ-R2 | TTTCACTTCTGAGTTGGCATGGGGTCAGG | |
| yccT-FLAG-BAD-F | GACTACAAAGACCAT GTGCCTGTGCGCAGG | |
| yccT-FLAG-BAD-R | TTTATCGTCGTCATC TGTTTTTCCGCCCAC | |
| Flag-check-R2 | AGCGTGGTCATAGGTAGCTCCTGTCAAAAGACCGC | |
| yccT-SPdel-F | ACCTATGACCACGCT TTTCAACCGATGTCG | |
| yccT-SPdel-R | AGCGTGGTCATAGGT CTGTCAAAAGACCGC | |
| BAD-24-SQ-F | TTTATCCATAAGATTAGCGGATCCTACCTG | |
| BAD-24-SQ-R | ATCTGTATCAGGCTGAAAATCTTCTCTCAT | |
| pBAD24-inversePCR-F | TACCCGGGGATCCTCTAGAGTCGACCTGCAGGCAT | |
| pBAD24-inversePCR-R2 | GGTGAATTCCTCCTGCTAGCCCAAAAAAACGGGTA | |
| yccT-infusion-pBAD24-F2 | CAGGAGGAATTCACCATGAAAACCGGCATCGTGAC | |
| dspyccT-infusion-pBAD24-F2 | CAGGAGGAATTCACCATGACCACGCTGCTGCGCGG | |
| yccT-infusion-R | TTCGCCTTTCGACATGGAAGATGGTTGTTTTTCCG | |
| sfGFP-infusion-F | AAACAACCATCTTCCATGTCGAAAGGCGAAGAACT | |
| sfGFP-infusion-p24-F | CAGGAGGAATTCACCATGTCGAAAGGCGAAGAACT | |
| sfGFP-infusion-R | GAGGATCCCCGGGTATTATACAGCTCATCCATACC | |
Disclaimer/Publisher’s Note: The statements, opinions and data contained in all publications are solely those of the individual author(s) and contributor(s) and not of MDPI and/or the editor(s). MDPI and/or the editor(s) disclaim responsibility for any injury to people or property resulting from any ideas, methods, instructions or products referred to in the content. |
© 2023 by the authors. Licensee MDPI, Basel, Switzerland. This article is an open access article distributed under the terms and conditions of the Creative Commons Attribution (CC BY) license (https://creativecommons.org/licenses/by/4.0/).
Share and Cite
Sano, K.; Kobayashi, H.; Chuta, H.; Matsuyoshi, N.; Kato, Y.; Ogasawara, H. CsgI (YccT) Is a Novel Inhibitor of Curli Fimbriae Formation in Escherichia coli Preventing CsgA Polymerization and Curli Gene Expression. Int. J. Mol. Sci. 2023, 24, 4357. https://doi.org/10.3390/ijms24054357
Sano K, Kobayashi H, Chuta H, Matsuyoshi N, Kato Y, Ogasawara H. CsgI (YccT) Is a Novel Inhibitor of Curli Fimbriae Formation in Escherichia coli Preventing CsgA Polymerization and Curli Gene Expression. International Journal of Molecular Sciences. 2023; 24(5):4357. https://doi.org/10.3390/ijms24054357
Chicago/Turabian StyleSano, Kotaro, Hiroaki Kobayashi, Hirotaka Chuta, Nozomi Matsuyoshi, Yuki Kato, and Hiroshi Ogasawara. 2023. "CsgI (YccT) Is a Novel Inhibitor of Curli Fimbriae Formation in Escherichia coli Preventing CsgA Polymerization and Curli Gene Expression" International Journal of Molecular Sciences 24, no. 5: 4357. https://doi.org/10.3390/ijms24054357
APA StyleSano, K., Kobayashi, H., Chuta, H., Matsuyoshi, N., Kato, Y., & Ogasawara, H. (2023). CsgI (YccT) Is a Novel Inhibitor of Curli Fimbriae Formation in Escherichia coli Preventing CsgA Polymerization and Curli Gene Expression. International Journal of Molecular Sciences, 24(5), 4357. https://doi.org/10.3390/ijms24054357

